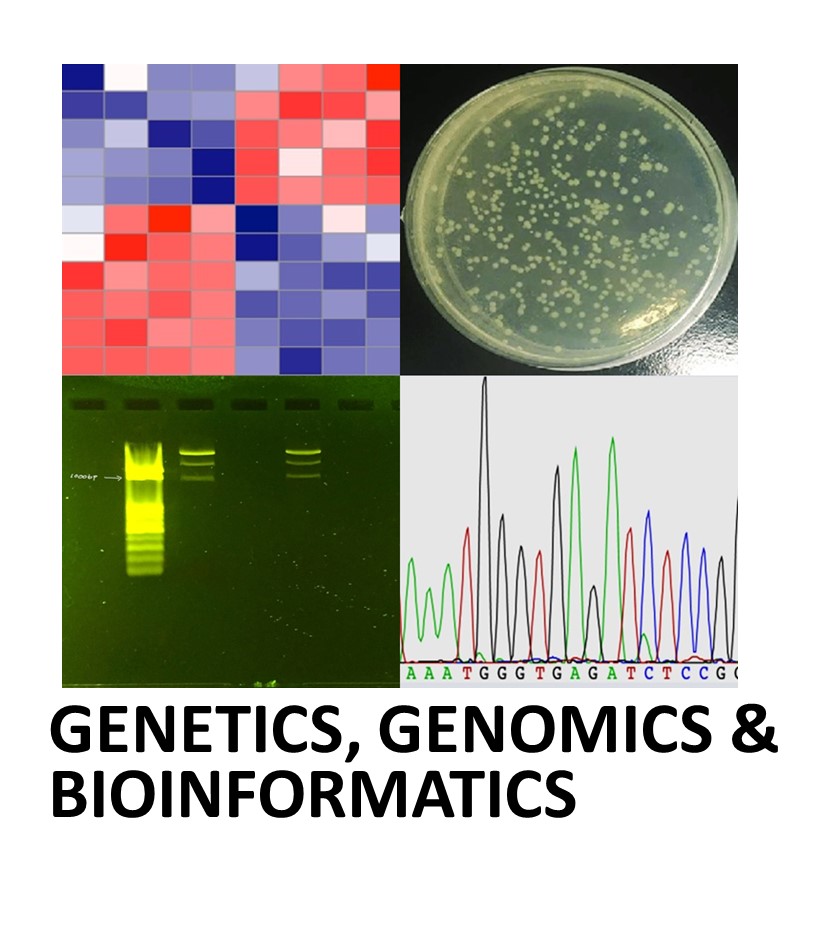

Biological Sciences
Research Areas
The Department of Biological Sciences emphasizes the integrative nature of the biological
sciences, focusing on programs that unite four major areas: Cellular & Molecular Biology;
Ecology, Evolution, & Conservation Biology; Genetics, Genomics, & Bioinformatics;
and Physiology & Behavior.
Faculty research programs reflect the interdisciplinary strength of our department,
while providing a firm foundation in theoretical focal areas. Recent faculty hires
support our rich tradition of research training in these traditional fundamental disciplines
while providing the specializations to foster interdisciplinary relationships.
Faculty and Student Publications
![]() |
Cell & Molecular BiologyAmy Abell: Epigenetic regulation of gene expression, EMT, signaling networks |
![]() |
Ecology, Evolution, & Conservation BiologyJim Adelman: Avian disease ecology, ecological immunology, behavior |
![]() |
Genetics, Genomics & BioinformaticsShawn Brown: Microbial ecology, environmental microbiology, mycology |
![]() |
Physiology & BehaviorJim Adelman: Avian disease ecology, ecological immunology, behavior |